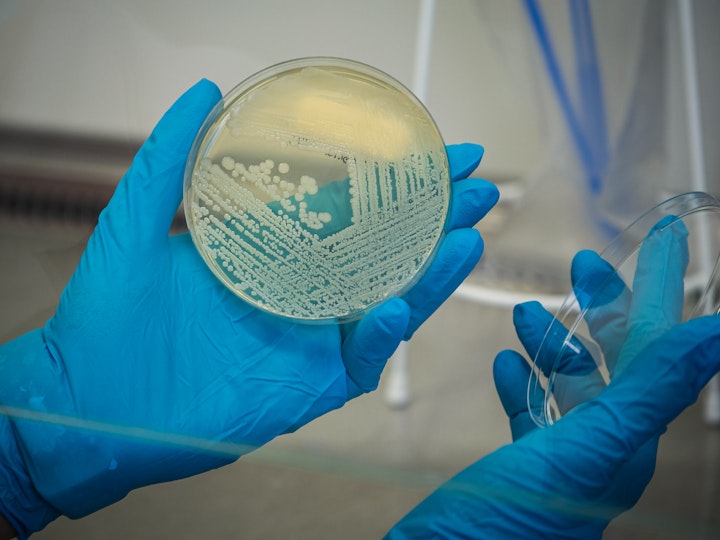

Mirza Duraković
Photographer | Filmmaker | Writer

Corporate
Corporate
Photos and videos shot for the Calouste Gulbenkian Foundation, Altar, a biotechnology company which develops and commercializes innovative solutions in the field of automated genetics in millilitre-scale fluidics, and Alvie, a startup that develops a solution based on sensors and an artificial intelligence platform to help farmers modulate pesticide doses according to weather conditions.
--
All photographs and videos by Mirza Durakovic
©2021 Mirza Durakovic